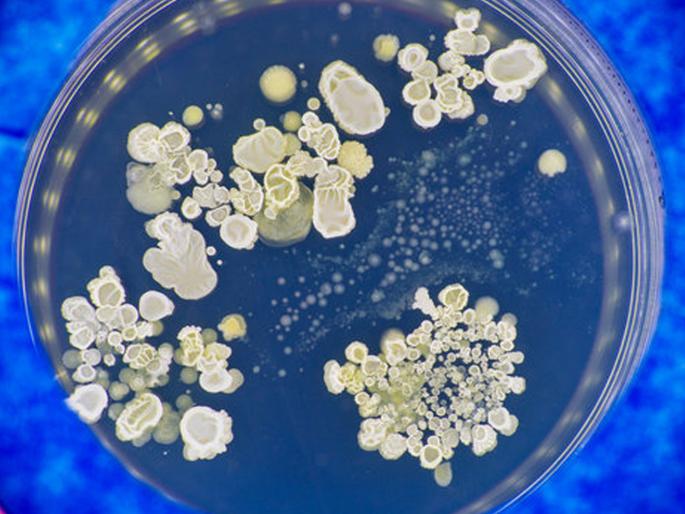
experts claims that fungi could be the source of our next pandemic | धोका ओळखा! पुढील महामारीचे कारण बुरशी ठरू शकते; संशोधनानंतर तज्ज्ञांचा मोठा दावा experts claims that fungi could be the source of our next pandemic | धोका ओळखा! पुढील महामारीचे कारण बुरशी ठरू शकते; संशोधनानंतर तज्ज्ञांचा मोठा दावा

धोका ओळखा! पुढील महामारीचे कारण बुरशी ठरू शकते; संशोधनानंतर तज्ज्ञांचा मोठा दावा
By ऑनलाइन लोकमत | Updated: April 7, 2022 12:05 IST2022-04-07T12:04:31+5:302022-04-07T12:05:35+5:30
एकीकडे कोरोनाच्या तडाख्यातून जग सावरत असताना, गंभीर तसेच घातक बुरशीजन्य विषाणू संसर्गाचा इशारा तज्ज्ञांकडून देण्यात आला आहे.
धोका ओळखा! पुढील महामारीचे कारण बुरशी ठरू शकते; संशोधनानंतर तज्ज्ञांचा मोठा दावा
गेल्या दोन वर्षांपासून कोरोनाचा जगभरात धुमाकूळ सुरूच आहे. कोरोनाच्या अनेक लाटा एकामागून एक धडकत असून, त्याचे परिणाम काही देशांमध्ये तीव्र असल्याचे पाहायला मिळत आहे. डेल्टा, ओमायक्रॉन, डेल्टाक्रॉन यांसारख्या अनेकविध व्हेरिएंटनंतर आता आणि नवा कोरोनाचा व्हेरिएंट समोर आला आहे. कोरोनाच्या महामारीपासून जग काही प्रमाणात सावरत असताना तज्ज्ञांनी आणखी एक धोक्याचा इशारा दिला आहे. पृथ्वीवरील पुढील महामारीचे कारण बुरशी ठरू शकते, असा दावा तज्ज्ञांनी केला आहे.
कोरोनामुळे वन्यजीवांमधील किंवा वन्यजीवांपासून मानवाला धोका निर्माण होणाऱ्या विषाणूंबाबत आंतरराष्ट्रीय स्तरावर जागरूकता निर्माण करण्यात आली असली तरी बुरशीसारख्या सूक्ष्मजीवांमुळे होणारे आजार, धोके यांकडे दुर्लक्ष करता येणार नाही. किंबहुना ते करून चालणार नाही, असेही तज्ज्ञांनी म्हटले आहे. सन २०२१ च्या मध्यात कोरोनाची गंभीर प्रकरणे असलेल्या आणि व्हायरसपासून बरे झालेल्या रुग्णांमध्ये गंभीर बुरशीजन्य संसर्गाचा अहवाल समोर आला. रुग्णांना एस्परगिलोसिस नावाच्या साच्यापासून श्वसन संक्रमणाचे निदान झाले. विशेषतः भारतात एक गंभीर परंतु दुर्मिळ बुरशीजन्य संसर्ग म्युकरमायकोसिस आढळून आला होता. याचे गंभीर परिणाम दिसून आले असून, परिणामी मृत्यूही ओढावू शकतो.
अमेरिकेतही बुरशीमुळे गंभीर आजार
कोरोनाचा अमेरिकेत धुमाकूळ सुरू आहे. तसेच दक्षिण-पश्चिम अमेरिका, मध्य आणि दक्षिण अमेरिका येथे बुरशी संसर्गामुळे ताप येण्याचे प्रकार समोर आले आहेत. बुरशीचा संसर्ग हा बहुतांश प्रमाणात दुषित मातीमुळे होत असल्याचे समोर आल्याचे तज्ज्ञांनी नमूद केले आहे. प्रदुषण, वातावरणीय बदल आणि भौगोलिक परिस्थिती यामुळे बुरशीमुळे होणाऱ्या संसर्गात वाढ होत चालल्याचे सांगितले जात आहे. बुरशीजन्य विषाणू असलेल्या मातीच्या धुळीमुळे श्वास घेतल्यानंतर ताप येतो. हवामान बदलामुळे वारंवार दुष्काळ पडतो, ज्यामुळे अधिक धूळ निर्माण होते आणि भूकंपामुळे इमारतींच्या बांधकामामुळे धूळ अधिक प्रमाणात पसरते. एकत्रितपणे, या घटकांमुळे बुरशीजन्य संसर्गामुळे होणाऱ्या आजारांचे प्रमाण वाढत असल्याचे निदर्शनास आले आहे.
कँडिडा ऑरिसचा नवा धोका
कँडिडा ऑरिस हा एक आक्रमक विषाणूचा प्रकार असून, याच्या संसर्गामुळे परिणामी मृत्यूही होऊ शकतो. हा नवीन साथीच्या रोगाचा सर्वांत मोठा धोका आहे. मानवामुळे हवामान बदलातून उद्भवलेल्या नवीन प्राणघातक रोगजनकाचे हे पहिले उदाहरण असू शकते. कारण ते तीन खंडांवर एकाच वेळी दिसले असून, केवळ मोठ्या प्रमाणात पर्यावरणीय बदलाद्वारे होऊ शकते, असे सांगितले जात आहे. सन २००९ मध्ये प्रथम हा संसर्गजन्य विषाणू आढळून आला होता. कँडिडा ऑरिसचा एका व्यक्तीपासून दुसऱ्या व्यक्तीला थेट संसर्ग होण्याचा पुरावा नाही. परंतु वातावरणात, पृष्ठभागांवर आणि दैनंदिन वस्तूंवर हा विषाणू टिकून राहतो. तसेच हा विषाणू वेगाने पसरतो, असेही तज्ज्ञांनी म्हटले आहे.
दरम्यान, महामारीविज्ञान आणि हवामान डेटाची उपलब्धता आणि लोकसंख्येच्या सामाजिक असुरक्षा समजून घेणे, यामुळे सार्वजनिक जागरूकता वाढविण्यात आणि जोखीम असलेल्या गटांना लक्ष्य करण्यात मदत झाली आहे. प्राण्यांची संख्या, लोकसंख्या आणि पर्यावरणीय बदलाचे एकात्मिक निरीक्षण करणे आणि सार्वजनिक स्तरावरील आरोग्याचे शिक्षण बुरशीजन्य रोगांपासून दूर राहण्यास मदत करू शकते, असे तज्ज्ञांकडून सांगण्यात आले आहे.